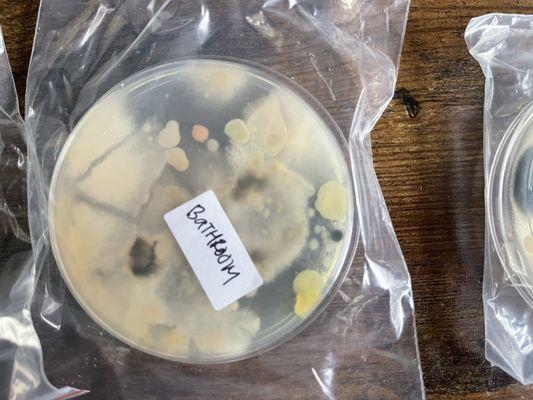
Nix Wealth Management

Akt Development Corporation
Closed
Advertisement
7700 College Town Dr
Sacramento, CA 95826
Akt Development Corporation is a prominent real estate agency located in Sacramento, CA. They specialize in a variety of property services, catering to both residential and commercial markets. With a commitment to client satisfaction and extensive local knowledge, they strive to facilitate seamless transactions and foster lasting relationships within the community.
Generated from this place's information
Also at this address
See a problem?
You might also like
Partial Data by Foursquare.
Advertisement